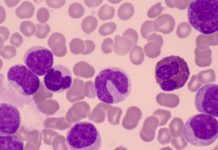
«Избирательное уничтожение»: российские учёные нашли способ разрушать раковые клетки изнутри

Сийярто: в ЕС препятствуют усилиям по урегулированию украинского конфликта
Значительная часть государств — членов ЕС препятствуют усилиям по урегулированию украинского конфликта.Об этом ТАСС сказал глава венгерского МИД Петер Сийярто.«На словах они могут быть...
Пашинян направил Путину соболезнования в связи с крушением самолёта Ан-24
Глава правительства Армении Никол Пашинян направил президенту России Владимиру Путину телеграмму с соболезнованиями в связи с крушением пассажирского самолёта Ан-24 в Амурской области.Об этом...
«Избирательное уничтожение»: российские учёные нашли способ разрушать раковые клетки изнутри
Российские учёные из МГУ имени М.В. Ломоносова разработали новую форму фермента L-аспарагиназа — важного препарата для лечения лимфобластного лейкоза. Исследователи присоединили к молекуле фермента...
ФСБ: арестованы 19 причастных к дистанционному мошенничеству в регионах России
В ФСБ сообщили об аресте 19 членов группы дистанционных мошенников, действовавших в четырёх регионах России.По данным ФСБ, группа действовала в Московской, Новосибирской, Томской областях...
Riformista встревожилась из-за показов RT в Италии, назвав их «путинской чумой»
Итальянская газета Il Riformista с тревогой пишет о мероприятиях в Италии, которые за последний год организовал RT. Издание опубликовало материал под заголовком «Путинская чума...